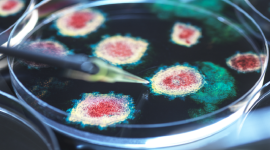

الصحة العالمية تحذر من جائحة وبائية جديدة شبيهة بـ"كوفيد-19"
وجه تيدروس أدهانوم غيبرييسوس، المدير العام لمنظمة الصحة العالمية، اليوم الثلاثاء، تحذيرا من احتمال ظهور جائحة جديدة شبيهة بجائحة "كوفيد-19".

الصحة العالمية: "كوفيد-19" يقتل 1700 شخص أسبوعيا
أعلنت منظمة الصحة العالمية أن كوفيد-19 لا زال يودي بحياة نحو 1700 شخص أسبوعيا في أنحاء العالم، داعية الأشخاص الأكثر عرضة لخطر الإصابة لمواصلة تلقي اللقاح.